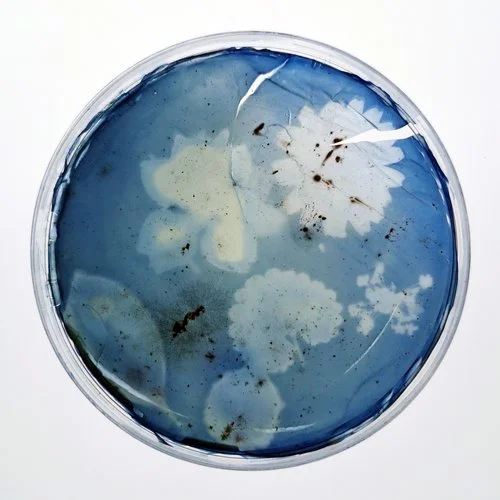
2.jpg
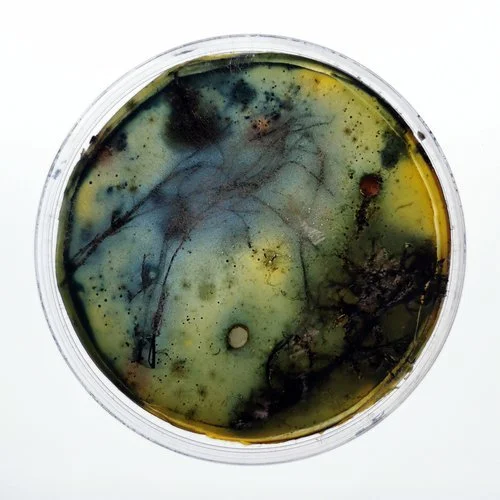
10.jpg
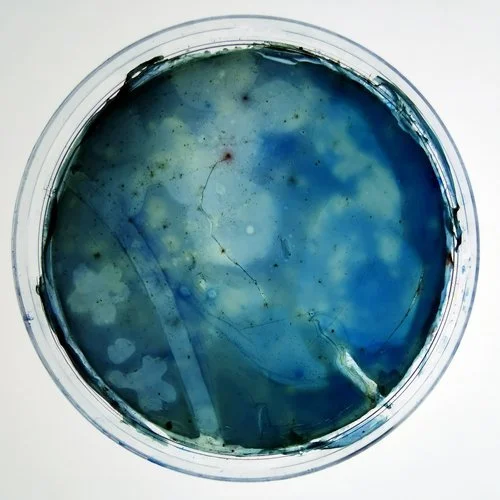
6.jpg
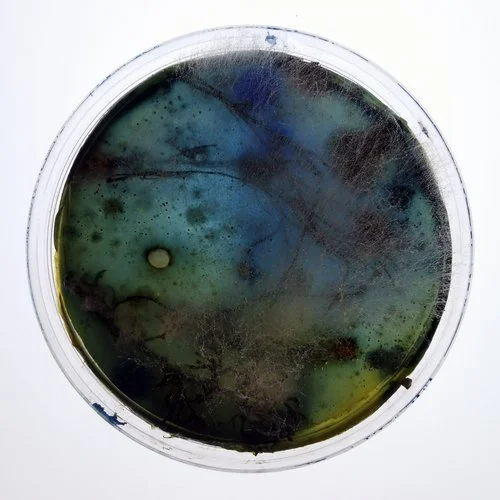
17.jpg
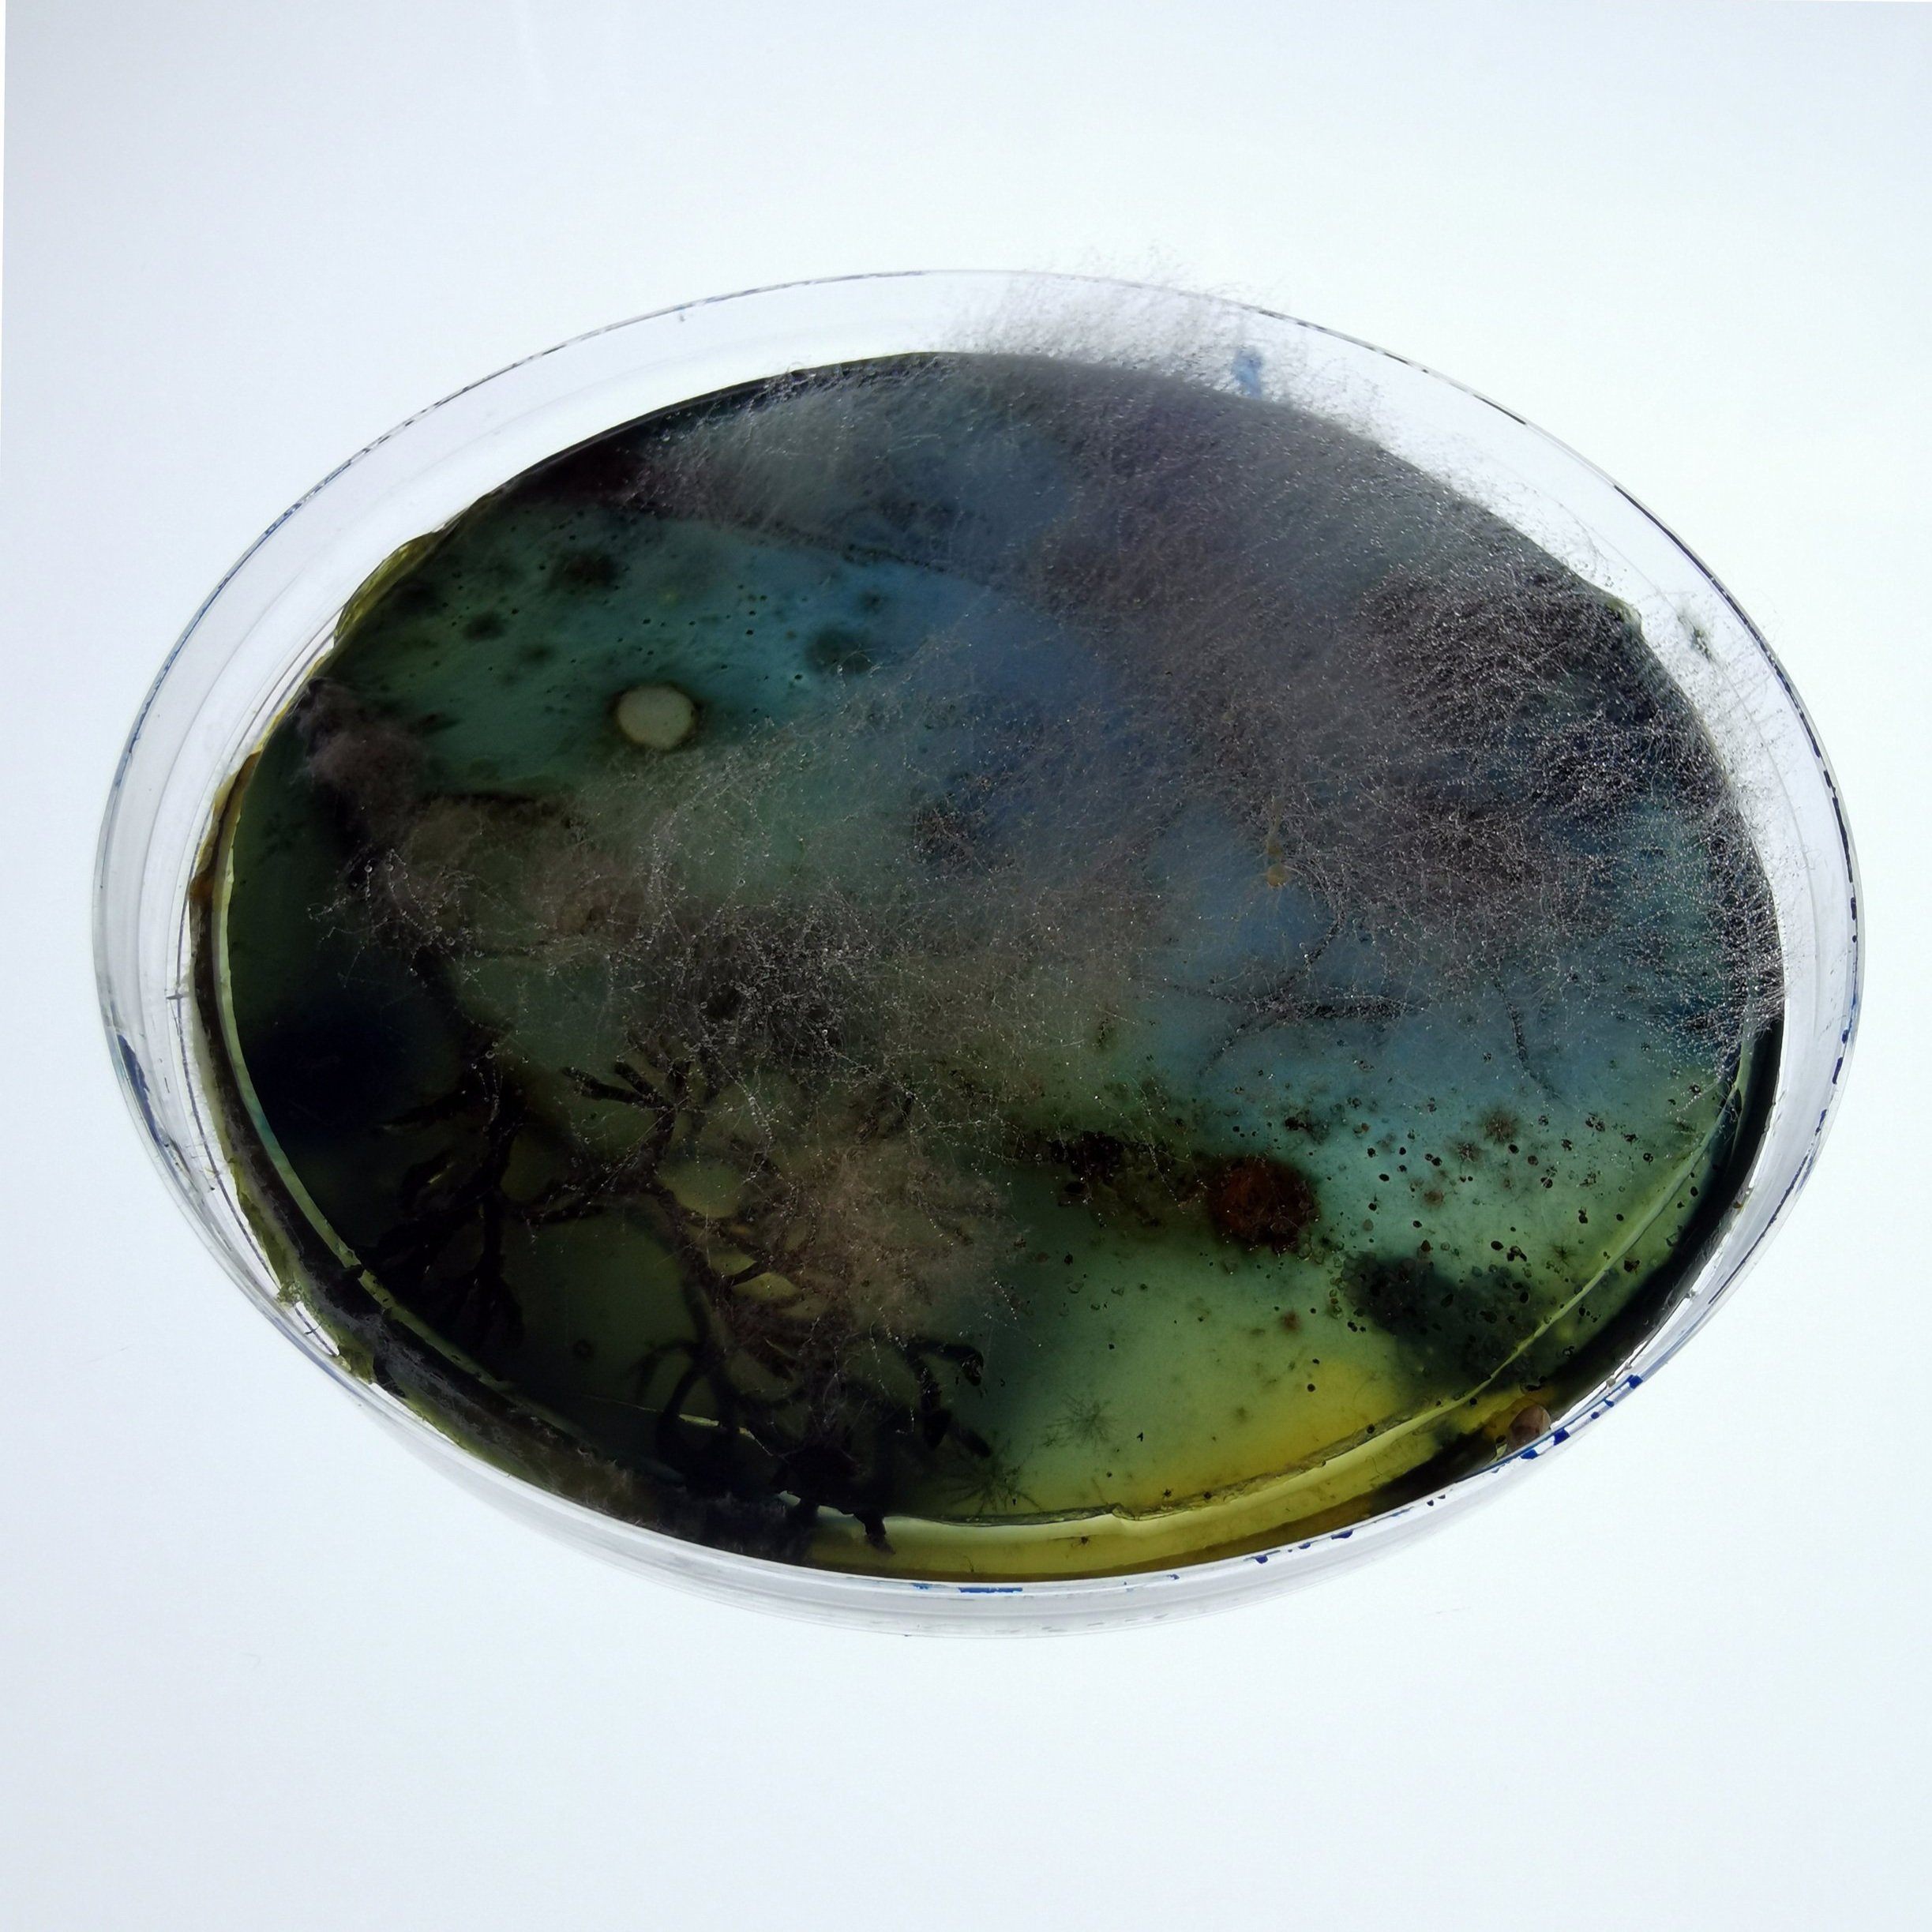
16.jpg
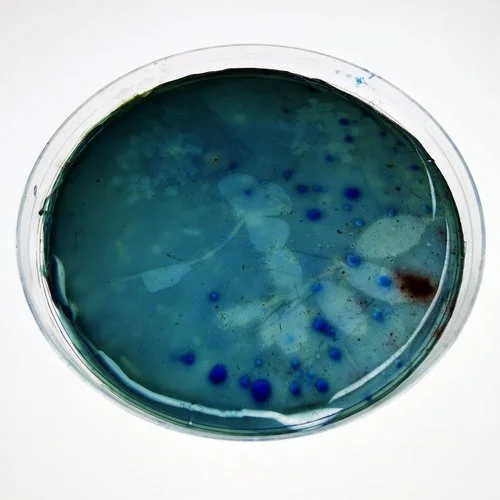
3.jpg
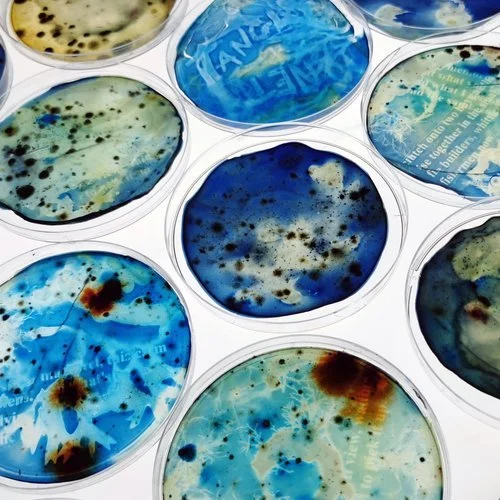
FIX_077.jpg
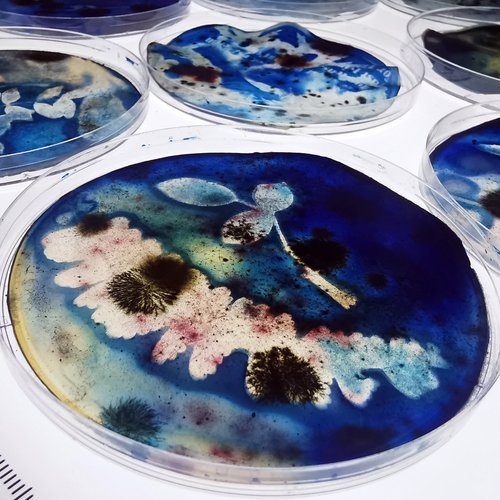
FIX_080.jpg
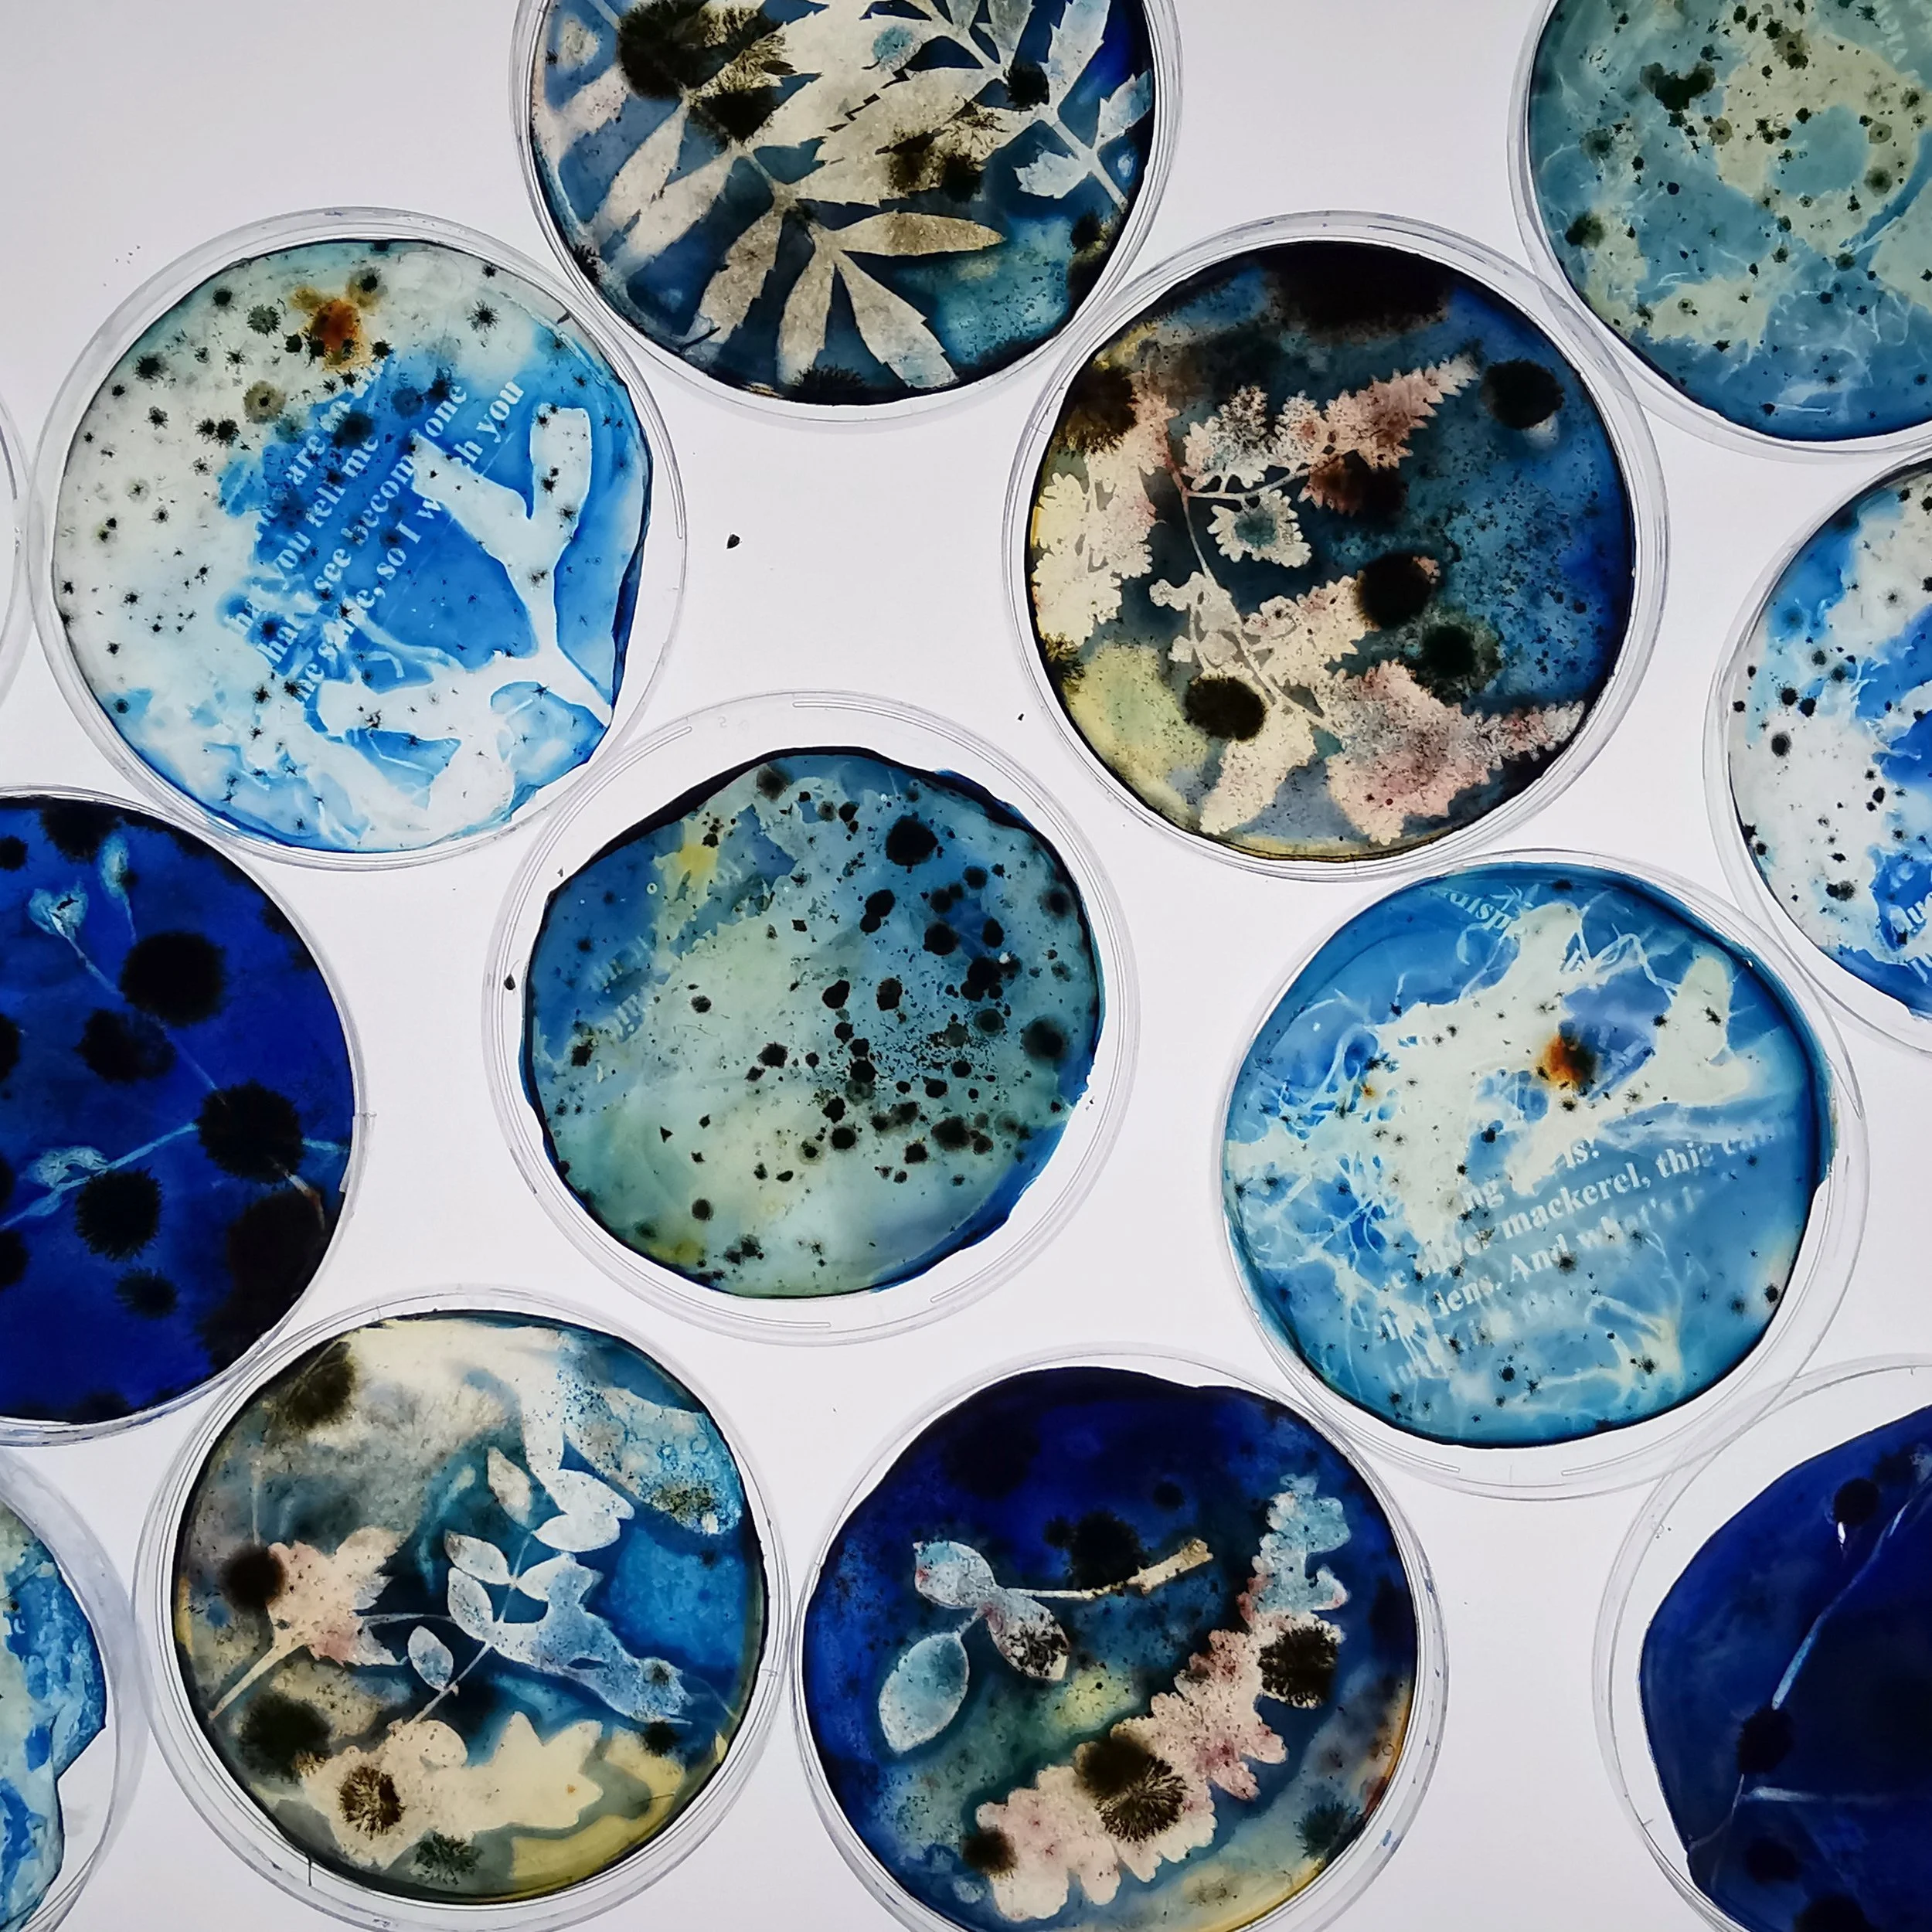
FIX_084.jpg
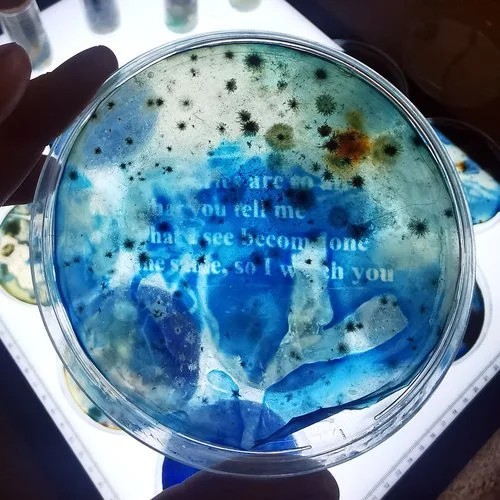
FIX_072.jpg
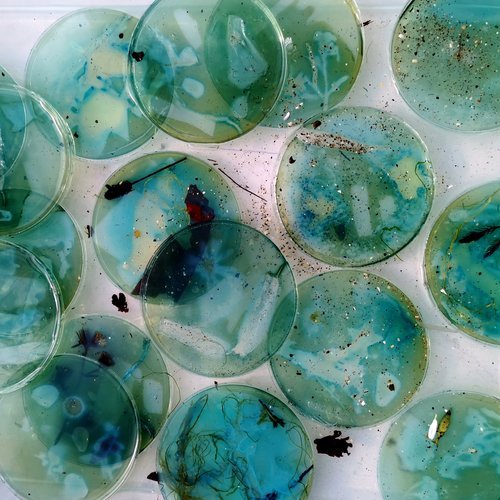
FIX_065.jpg

FIX | COP26
In tandem with INTO THE OCEANIC, an immersive project commissioned for COP26 in Glasgow by artists Elizabeth Ogilvie & Robert Page, I led a series of public engagement workshops with young people from four schools along Fife’s diverse coastline. These activities generated creative responses to the coastal environment and critical reflection on our relationship with the sea.
Lockdown offered a unique opportunity to reconnect with immediate surroundings and rediscover a sense of wonder within familiar landscapes.
Fife's coastline has a rich industrial heritage, including a kelp industry dating back to the 1600s that supported advancements in various sectors like glass, pottery, soap, textiles and agriculture. Many 18th and 19th-century alternative photography processes have remained relatively underexplored due to accelerated advancements in early photography.
Our approach involved foraging for materials in an ‘open air’ coastal studio and experimenting with these sustainable, camera-less photographic techniques.
We foraged for materials in an ‘open air’ coastal studio and experimented with alternative photography techniques that required no harsh chemicals or camera equipment – achieving sustainable results using a ‘green dark room’ and through fascinating processes reliant on the natural alchemical qualities of coastal plant life and sea salt.
Participants made use of ‘defunct’ out of date B&W photographic paper and incorporated locally foraged seaweed and plants to make natural photographic emulsions and developers. They also explored slow photography techniques, such as cyanotypes on petri dishes filled with algae, swabbing the tideline, and seeing how the growing cultures creep, disrupt and eventually destroy their images over time.
Groups experimented with the creation of anthotypes, lumens, cyanolumens and chemigrams, fixing their images using locally harvested sea salt and ‘souping’ our images with a mixture of acidic and alkaline household contaminants to mimic changes in our oceans.
These explorations incorporated the making of cordage from foraged coastal weeds and grasses, incorporating these creations into our ‘plummet’ samples. They investigated themes of impermanence, life cycles, and human impact on the natural world (often invisible to the naked eye).
By utilising readily available materials and safe processes, this project aimed to democratise access to photographic techniques, which in turn allowed a greater understanding of ecology and the world around us.
Moving away from harmful chemicals and embracing sustainable alternatives has the potential to widen access to photography and minimise its environmental impact. This green approach fosters a more inclusive and sustainable practice, acting as a stimulus for exciting innovations in photography that resonate with contemporary environmental and social concerns.
~
With special thanks to Darren Peattie from East Neuk Salt Co. for donating his beautiful local salt for this project; Jayson Byles from East Neuk Seaweed for sharing his seaweed foraging expertise; Susan McGuire (care experience coordinator at Fife College) for her invaluable assistance; and all of the participating students from Madras College, Levenmouth Academy, Waid Academy & Lundin Mill Primary School in Fife, all of whom approached the project with great enthusiasm!